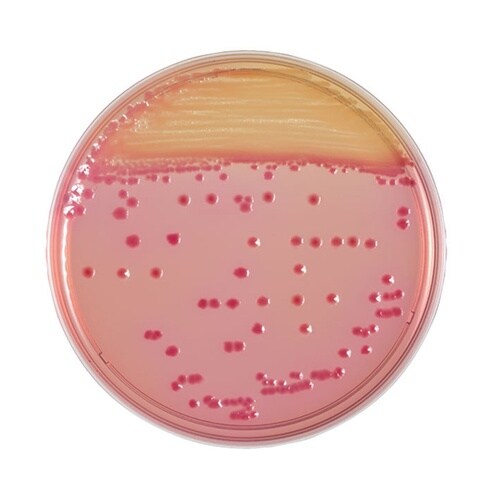
251139 BBLCIN寒天培地20枚

入数 1個 販売価格 ¥5,475 (税込)
培地関連用品の売れ筋ランキング
- ¥6,030(税込) (税込)
- ¥3,135(税込) (税込)
- ¥2,090(税込) (税込)
商品の特徴 |
CIN 寒天培地は、検査材料からのYersinia の選択分離培地です。Y. enterocolitica は24−48時間培養で本培地上に平滑、赤色、湿潤でやや膨隆、コロニーの周辺が白色をおびた特徴 |
|---|---|
商品仕様 |
|
メーカー情報 |
|
カタログ掲載ページ |
-/- |
| 注意事項 | ※【返品に関するご注意】この商品は直送品のため、お客様のご都合による返品はお受けできません。 |
|---|